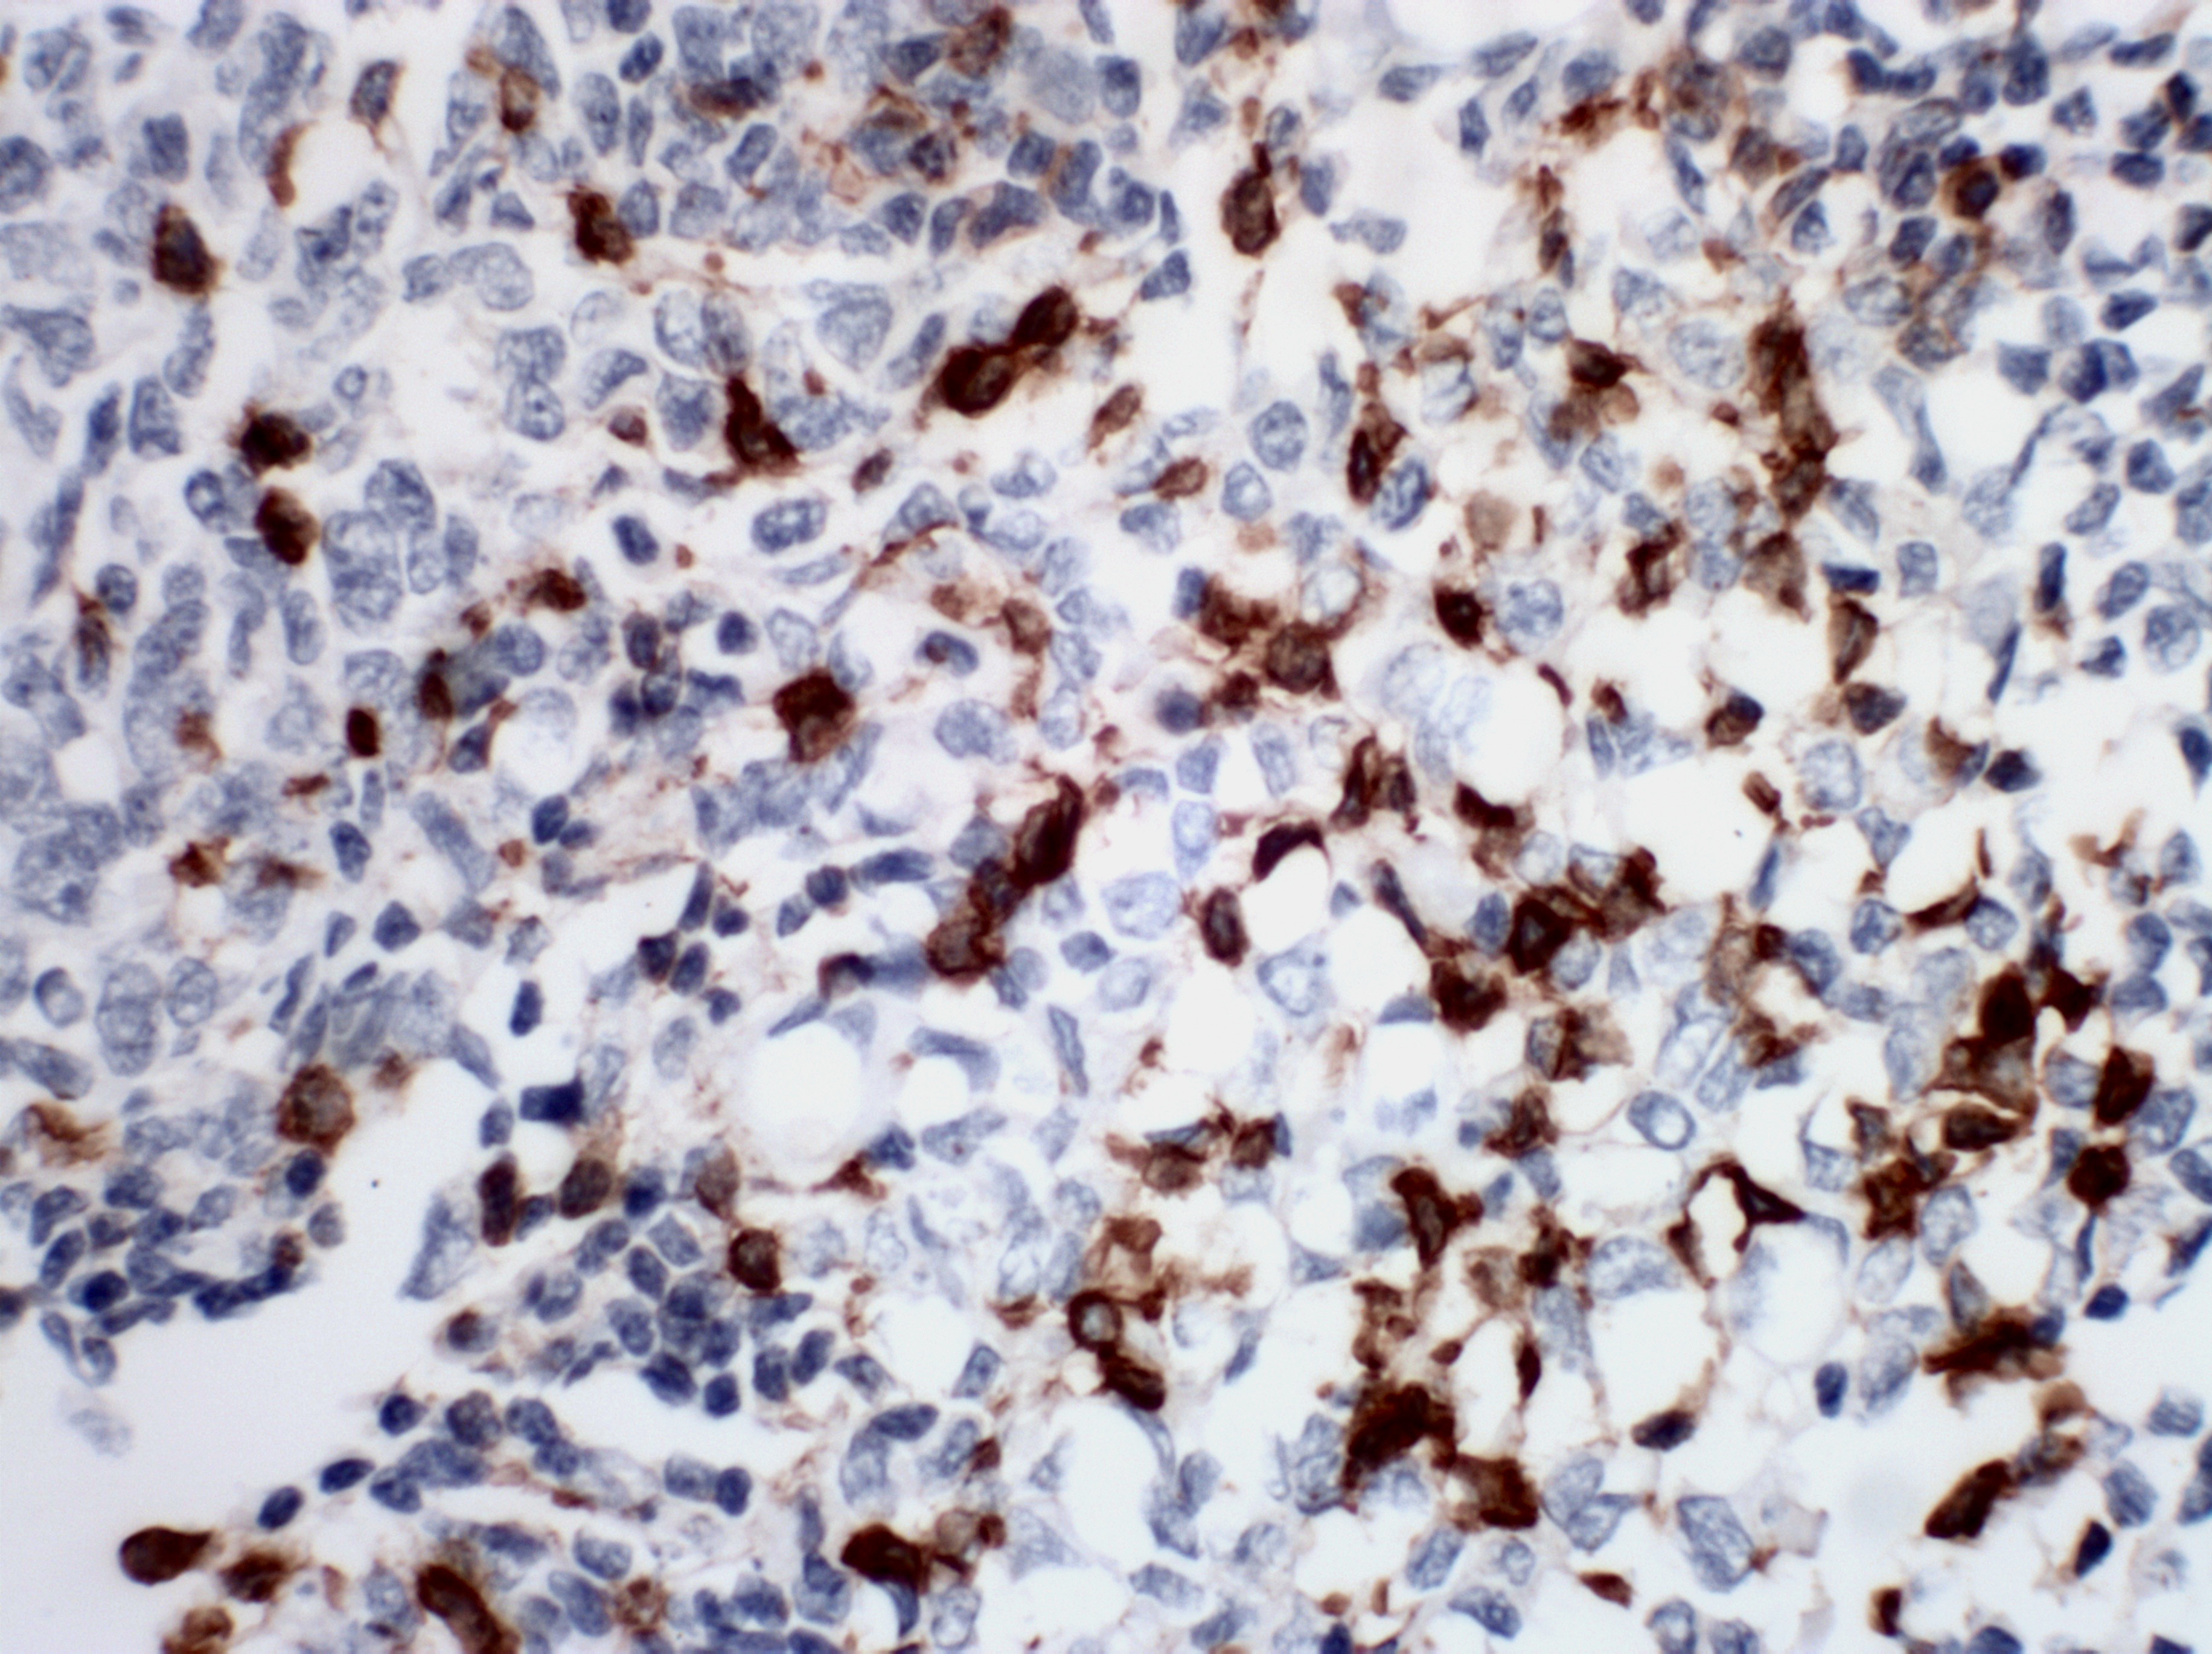

test
iubs saibcui sdcibasud cisadubc jsdknc sdhcj sdchasdjbusjnc hsd iusadjc biasuv jsmciasd vulha
Introduction
iubs saibcui sdcibasud cisadubc jsdknc sdhcj sdchasdjbusjnc hsd iusadjc biasuv jsmciasd vulha
Description
sukhcuisbcuisc isdb ciusd uisncoisdbviudjciaosjcasdivuiskcioscc ciusdbcisubcioasbcoidsab iscisbc iks
Ordering Information
| Catalog | Reactions |
|---|---|
| PR042-3ml | bu |
| sdug | buy |